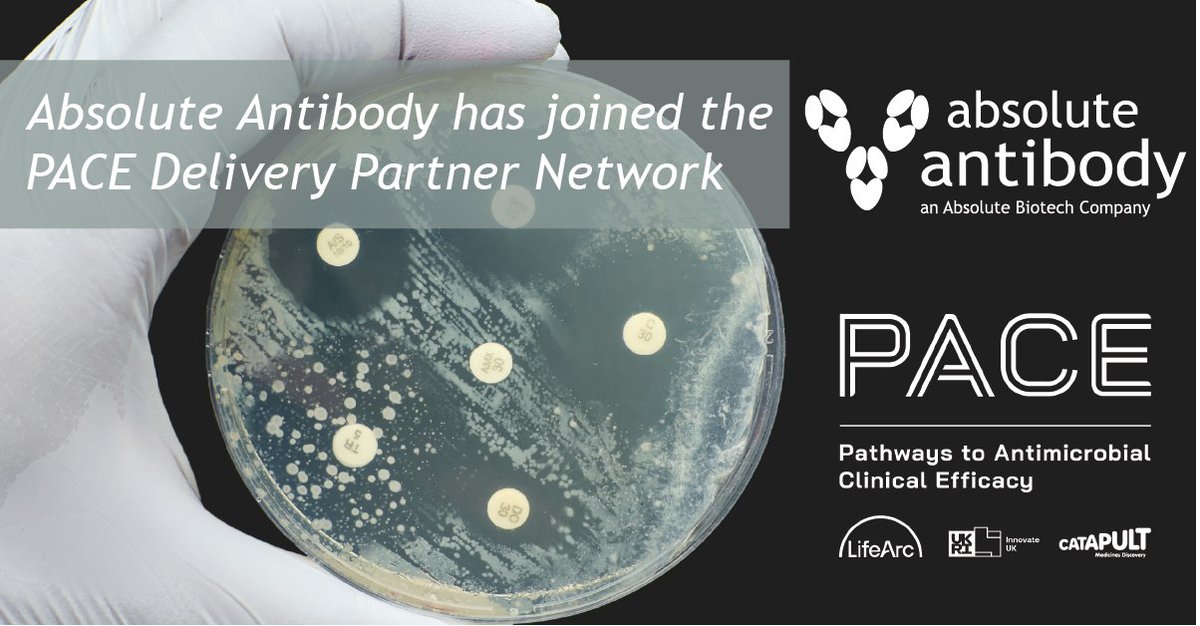
Absolute Antibody tweet media

Tweet fijado

We’re thrilled to merge with Vector Laboratories! This partnership will enhance our offerings and drive innovation in antibody solutions for the life sciences community. Stay tuned for more updates.
Vector Laboratories@VectorLabsUS
Vector Laboratories today announced its intention to merge with @AbsoluteBiotech, a unified company of multiple antibody-centric brands. The transaction is a milestone in our commitment to better serve life science customers. Read the full release: bit.ly/3QLfcRS
English